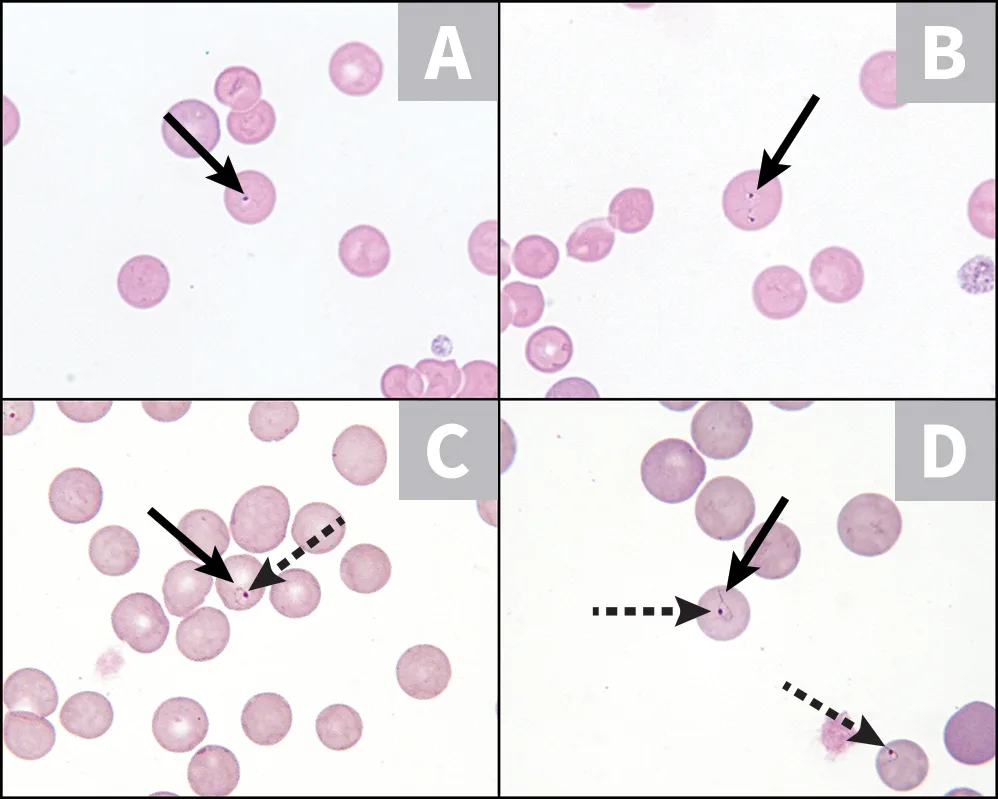
selected slide image

Babesiosis
Jennifer Neel, DVM, DACVP (Clinical Pathology), North Carolina State University

Babesia spp are a primarily tick-transmitted protozoan hemoparasite that infect a wide range of undomesticated (ie, wildlife) and domesticated vertebrate hosts, with >100 species reported. Unlike the closely related genus Theileria, Babesia spp do not have a schizont tissue phase; however, both genera have red cell phases that appear similar. Periodic reclassification or re-evaluation of species occurs as more is learned about their life cycles—for example, the reclassification of Babesia equi to Theileria equi with recognition of a lymphocyte schizont phase.1 Dogs are the most commonly affected domestic animals, and at least 7 infectious species (including B canis, B vogeli, B rossi, B gibsoni, B conradae, B vulpes, B negevi n sp, and several unnamed but genetically unique species) have been described.2 Babesia spp can be described as large-form (easily identified) or small-form (more challenging to recognize).3 Pathogenicity varies by species and host; signs range from subclinical disease to severe hemolytic anemia.4
Morphology, clinical signs, species infected, and location can be used for tentative identification of a likely organism; however, molecular techniques are necessary for specific identification.5 The same organism may exhibit morphologic differences when infecting different host species.6 Pathogenicity can vary depending on the specific organism, species infected, and host factors (eg, immunocompromised state). Despite the usefulness of blood smear identification, molecular and serologic techniques are critical, as organisms may be missed on blood smear examination or may be present in levels too low for visual detection. In addition, genetic analysis allows characterization of new species and reclassification of known organisms. New clinical syndromes will emerge as geographic territories for tick vectors expand and species are introduced into new territories and naive populations.
The following images include examples of Babesia spp organisms that affect dogs, wildlife, and laboratory animals.
FIGURE 1
Blood smear from a dog with Babesia gibsoni, a classic, small-form Babesia spp with a thin, blue cell membrane (A-D; solid arrows) and appears as small, oval to pleomorphic structures with an eccentric dotlike nucleus (C, D; dashed arrows). B gibsoni has worldwide distribution, can cause severe disease in dogs, and has been associated with secondary immune-mediated hemolytic anemia.7 In studies of samples submitted to infectious disease and international diagnostic laboratories, B gibsoni was the most commonly identified species affecting dogs.2,8 Quick Romanowsky stains are commonly used in the clinic and highlight visualization of organisms better than traditional Romanowsky stains. Wright Giemsa stain, a traditional Romanowsky stain, was used in A and B, and the cytoplasmic membrane is not highly visible. Quick Romanowsky stain was used in C and D, and the nucleus and cytoplasmic membrane are highly visible. This effect is enhanced when slides are slightly overstained with a dark-blue stain solution (solution II). Original magnification, 100× objective